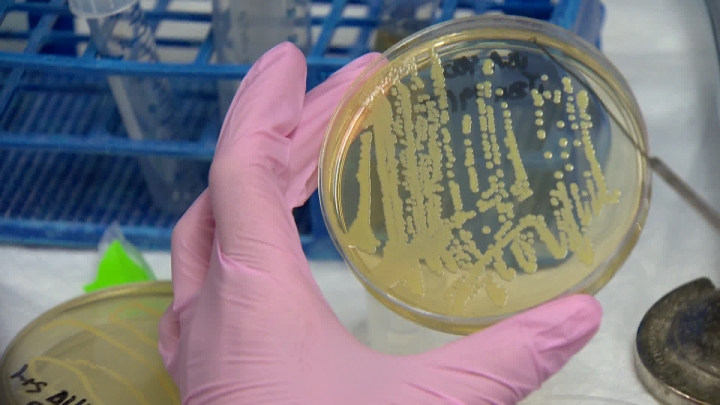

Researchers at the University of Calgary believe they have uncovered an important piece of information when it comes to understanding how drug withdrawal symptoms work in mice and rats, which may benefit humans.

A team of neuroscientists has identified a target in the spinal cord and brain they believe is responsible for opioid withdrawal symptoms.
That target seems to react to a common anti-gout medication to reduce those specific withdrawal symptoms from morphine and fentanyl.
In a release Monday, the university said prior to this study, the actual mechanism of opioid withdrawal was not really understood.
READ MORE: More Canadians babies born with opioid addiction and withdrawal
According to Nicole Burma, one of the researchers at the University of Calgary, they believe this off-label use of anti-gout medication could be significant in helping wean people off of opioids and are now working on developing a clinical trial with the Calgary Pain Clinic.
Burma said currently opioid withdrawal symptoms are treated with alternative opioids like methadone or suboxone, or through the use of clonidine, which has been proven to be relatively ineffective to date.
Researchers said the anti-gout medication is Health Canada-approved, and has few side effects. It also did not affect the ability of the opioid to relieve pain.
Currently opioids are one of the only medications available to help treat chronic pain, however they can cause severe withdrawal symptoms.
- B.C. to ban drug use in all public places in major overhaul of decriminalization
- 3 women diagnosed with HIV after ‘vampire facials’ at unlicensed U.S. spa
- Solar eclipse eye damage: More than 160 cases reported in Ontario, Quebec
- ‘Super lice’ are becoming more resistant to chemical shampoos. What to use instead
Burma told Global News they are likely at least two years away from clinical trials of the anti-gout medication for this purpose, however they are actively pursuing getting trial approval from Health Canada and the other necessary channels.
Background
According to the Canadian Institute for Health Information (CIHI), Canada is dealing with a public health crisis related to opioids.
They said there are more than 13 opioid poisonings resulting in hospitalizations a day in Canada including three visits per day in Alberta.
The CIHI said there has been an increase of 53 per cent in opioid related emergency department visits in Alberta from 2010-2011 to 2014-2015. According to Alberta Health, 338 Albertans have died from an apparent drug overdose related to fentanyl or another opioid from January to September 2016.
For more information click here.

Comments